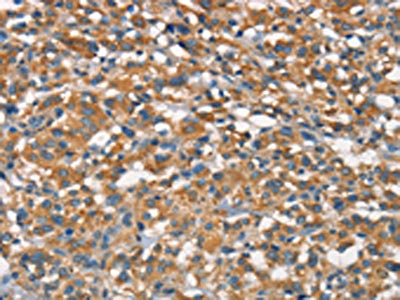

APOA1BP Antibody
-
中文名稱:APOA1BP兔多克隆抗體
-
貨號:CSB-PA163318
-
規格:¥1100
-
圖片:
-
The image on the left is immunohistochemistry of paraffin-embedded Human thyroid cancer tissue using CSB-PA163318(APOA1BP Antibody) at dilution 1/15, on the right is treated with synthetic peptide. (Original magnification: ×200)
-
The image on the left is immunohistochemistry of paraffin-embedded Human breast cancer tissue using CSB-PA163318(APOA1BP Antibody) at dilution 1/15, on the right is treated with synthetic peptide. (Original magnification: ×200)
-
-
其他:
產品詳情
-
Uniprot No.:
-
基因名:NAXE
-
別名:NAXE antibody; AIBP antibody; APOA1BP antibody; YJEFN1 antibody; NAD(P)H-hydrate epimerase antibody; EC 5.1.99.6 antibody; Apolipoprotein A-I-binding protein antibody; AI-BP antibody; NAD(P)HX epimerase antibody; YjeF N-terminal domain-containing protein 1 antibody; YjeF_N1 antibody
-
宿主:Rabbit
-
反應種屬:Human,Mouse,Rat
-
免疫原:Synthetic peptide of Human APOA1BP
-
免疫原種屬:Homo sapiens (Human)
-
標記方式:Non-conjugated
-
抗體亞型:IgG
-
純化方式:Antigen affinity purification
-
濃度:It differs from different batches. Please contact us to confirm it.
-
保存緩沖液:-20°C, pH7.4 PBS, 0.05% NaN3, 40% Glycerol
-
產品提供形式:Liquid
-
應用范圍:ELISA,IHC
-
推薦稀釋比:
Application Recommended Dilution ELISA 1:1000-1:2000 IHC 1:15-1:50 -
Protocols:
-
儲存條件:Upon receipt, store at -20°C or -80°C. Avoid repeated freeze.
-
貨期:Basically, we can dispatch the products out in 1-3 working days after receiving your orders. Delivery time maybe differs from different purchasing way or location, please kindly consult your local distributors for specific delivery time.
-
用途:For Research Use Only. Not for use in diagnostic or therapeutic procedures.
相關產品
靶點詳情
-
功能:Catalyzes the epimerization of the S- and R-forms of NAD(P)HX, a damaged form of NAD(P)H that is a result of enzymatic or heat-dependent hydration. This is a prerequisite for the S-specific NAD(P)H-hydrate dehydratase to allow the repair of both epimers of NAD(P)HX. Accelerates cholesterol efflux from endothelial cells to high-density lipoprotein (HDL) and thereby regulates angiogenesis.
-
基因功能參考文獻:
- NAXE gene mutations are associated with early-onset progressive encephalopathy. PMID: 30022751
- Study shows a homozygous mutation in the APOA1BP is associated with a lethal infantile leukoencephalopathy.This is the first report of a defect in the nicotinamide nucleotide repair system in humans. PMID: 27122014
- NAXE Mutations Disrupt the Cellular NAD(P)HX Repair System and Cause a Lethal Neurometabolic Disorder of Early Childhood PMID: 27616477
- AIBp contributes to mitotic entry and bipolar spindle assembly. PMID: 26114227
- AIBP accelerates cholesterol efflux from endothelial cells to HDL and thereby regulates angiogenesis PMID: 23719382
- Taken together, the current study demonstrates that APN might protect against atherosclerosis by increasing HDL assembly through enhancing ABCA1 pathway and apoA-1 synthesis in the liver. PMID: 17521614
顯示更多
收起更多
-
相關疾病:Encephalopathy, progressive, early-onset, with brain edema and/or leukoencephalopathy (PEBEL)
-
亞細胞定位:Mitochondrion. Secreted.
-
蛋白家族:NnrE/AIBP family
-
組織特異性:Ubiquitously expressed, with highest levels in kidney, heart and liver. Present in cerebrospinal fluid and urine but not in serum from healthy patients. Present in serum of sepsis patients (at protein level).
-
數據庫鏈接:
Most popular with customers
-
-
YWHAB Recombinant Monoclonal Antibody
Applications: ELISA, WB, IHC, IF, FC
Species Reactivity: Human, Mouse, Rat
-
Phospho-YAP1 (S127) Recombinant Monoclonal Antibody
Applications: ELISA, WB, IHC
Species Reactivity: Human
-
-
-
-
-